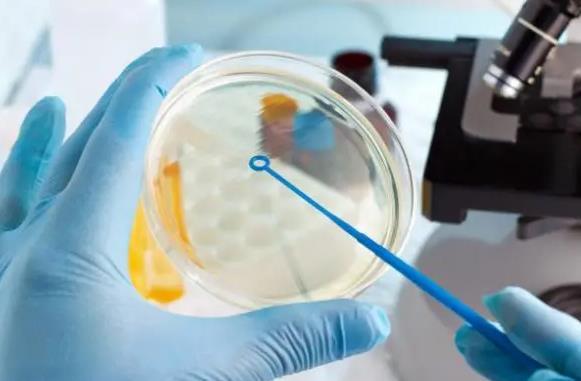
现在武汉做试管婴儿，有没有推荐的医院？

更新时间:2023-05-03
问题描述:
我患有双侧输卵管炎,想要尝试试管婴儿,想知道在武汉有没有专业的医院推荐?我的年龄是32岁,已经结婚5年无孕。最近进行了检查发现我的双侧输卵管都有炎症,怎么办?精选回答:
非常遗憾地听到您的身体情况。双侧输卵管炎是一种常见的妇科疾病,不仅会影响生育能力,还会导致不适和疼痛等不良反应。
针对您的问题,在武汉市有多家专业的生殖医学中心可以为您提供试管婴儿治疗服务。下面我们就为您介绍几家值得推荐的医院。
1.武汉华美丽致生殖医学中心
作为国内较早开展人类试管婴儿技术的单位之一,该中心拥有全面、成熟、专业和先进的技术设备及管理模式,并且聘请了多位国内着名生殖专家组成强大团队为患者提供优质服务。同时该中心还拥有一批经验丰富的医护人员,可以根据患者的具体情况提供个性化、全方位的治疗方案。
2.武汉大学人民医院生殖中心
该中心是武汉地区最早成立的生殖专业机构之一,也是武汉市试管婴儿技术领域内的重要力量。该中心拥有一批高素质、高水平的专家团队以及各种先进设备,能够为患者提供全面、专业和优质的试管婴儿治疗服务。
3.武汉协和医院生殖医学中心
作为一所三级综合性医院,武汉协和医院生殖医学中心在试管婴儿领域处于国内领先地位。该中心聘请了多位知名专家组成了强大的团队,并且引进了国际上最先进的设备和技术,可以为患者提供最优质、最安全、最有效的生育治疗方案。
重点提示:
选择合适的试管婴儿医院需要综合考虑多个因素,包括对患者细致的诊断、个性化的治疗方案、专业的医护团队以及高水平的技术设备等。建议您在选择医院时多做比较,找到最适合自己的医院进行治疗。另外针对双侧输卵管炎这种情况,除了试管婴儿治疗外,还有其他一些方法可以尝试,例如药物治疗、中西医结合等方法。希望您能早日康复,并且成功怀孕生子。
以上就是医院招聘网小编为大家整理的《现在武汉做试管婴儿,有没有推荐的医院?》相关信息,希望大家喜欢。
内容版权声明:本网站部分内容由网上整理转发,如有侵权请联系管理员进行删除.